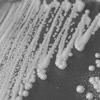
Image

For quotations, please use our online quotation form, and you may also contact us by
sales@neoscientific.com
+1-888.733.6849
+1-617.299.7367 (Int’l)
+1-888.733.6849
+1-617.299.7367 (Int’l)

Step 1: Gene Synthesis & Cloning
Amplification/isolation of the gene of interest
Sub-cloning into an expression vector(s)
Verification of gene sequence
Step 2: Pilot Expression Testing
Transformation of constructs into host cells
Small-scale expression of the target protein
Evaluation of optimal protein expression conditions
Step 3: Large-Scale Protein Expression & Purification
Large-scale growth of over-expressing cells
Protein purification by affinity, ion exchange, gel filtration, or hydrophobic interaction
SDS-PAGE or Western blot analysis of the purified protein
Determination of protein concentration
E. coli
Yeast
Insect
Mammalian
Gene synthesis
Cloning
Transformation
Expression & purification
In-house software
Codon optimization
Expression system evaluation
Systematic testing of expression conditions
We optimize the expression of your protein in several ways. Our proprietary in-house software allows the optimization of a gene according to a complex set of requirements in parallel. The software creates and evaluates numerous - often 10,000 or more - variants of a sequence, returning the optimal sequence that meets all requirements.
Once the sequence has been optimized and synthesized, we can evaluate numerous promoter systems and systematically test multiple variables including growth temperature, inducer concentration, and induction timing to increase protein expression. Customers receive detailed documentation of our optimization process and final expression conditions.
Once the optimal conditions are identified, larger quantities of protein are produced by scaling-up using these conditions. Oftentimes this process requires additional optimization to produce the highest expression levels. Our team has extensive experience with this process and has brought numerous expression and purification projects from small lab processes to gram level production.
NeoScientific can also produce your protein in >100g quantities. We can develop industrial scale batch or fed batch processes to meet all your large quantity needs.
Our protein biochemists employ an array of purification techniques to meet and exceed your purity requirements. We provide extensive documentation and QC results to ensure the highest quality product is returned to our customers. We routinely purify proteins using affinity, size-exclusion, hydrophobic interaction, ion-exchange and other techniques. Insoluble proteins can also be purified and refolded to the native state.
We can also perform various assays to characterize your protein for such things as stability, solubility, and function. Please consult one of our experienced representatives for details.
For most in vivo or cell culture studies, researchers require endotoxin free reagents. NeoBioLab can perform a protein polishing step to ensure that your purified protein is free of endotoxin and ready to use in your assays.